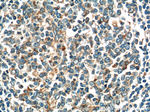
GAB2 Antibody in Immunohistochemistry (Paraffin) (IHC (P))

Search
Proteintech
GAB2 Polyclonal Antibody
{{$productOrderCtrl.translations['antibody.pdp.commerceCard.promotion.promotions']}}
{{$productOrderCtrl.translations['antibody.pdp.commerceCard.promotion.viewpromo']}}
{{$productOrderCtrl.translations['antibody.pdp.commerceCard.promotion.promocode']}}: {{promo.promoCode}} {{promo.promoTitle}} {{promo.promoDescription}}. {{$productOrderCtrl.translations['antibody.pdp.commerceCard.promotion.learnmore']}}
产品信息
22549-1-AP
种属反应
宿主/亚型
分类
类型
抗原
偶联物
形式
浓度
规格
纯化类型
保存液
内含物
保存条件
运输条件
产品详细信息
Immunogen sequence: SICQICGFN QAEESTDSLR NVSSAGHGPR SSPAELSSSS QHLLRERKSS APSHSSQPTL FTFEPPVSNH MQPTLSTSAP QEYLYLHQCI SRRAENARSA SFSQGTRASF LMRSDTAVQK LAQGNGHCVN GISGQVHGFY SLPKPSRHNT EFRDSTYDLP RSLASHGHTK GSLTGSETDN EDVYTFKTPS NTLCREFGDL LVDNMDVPAT PLSAYQIPRT FTLDKNHNAM TVATPGDSAI APPPRPPKPS QAETPRWGSP QQRPPISENS RSVAATIPRR NTLPAMDNSR LHRASSCETY EYPQRGGESA GRSAESMSDG VGSFLPGKMI VGRSDSTNSE D (111-450 aa encoded by BC131711)
靶标信息
This gene is a member of the GRB2-associated binding protein (GAB) gene family. These proteins contain pleckstrin homology (PH) domain, and bind SHP2 tyrosine phosphatase and GRB2 adapter protein. They act as adapters for transmitting various signals in response to stimuli through cytokine and growth factor receptors, and T- and B-cell antigen receptors. The protein encoded by this gene is the principal activator of phosphatidylinositol-3 kinase in response to activation of the high affinity IgE receptor. Two alternatively spliced transcripts encoding different isoforms have been described for this gene.
仅用于科研。不用于诊断过程。未经明确授权不得转售。
生物信息学
蛋白别名: Grb2 associated binder 2; GRB2-associated binder 2; GRB2-associated-binding protein 2; GRB3-3; Growth factor receptor bound protein 2-associated protein 2; PH domain-containing adaptor molecule p97; pp100
基因别名: AI463667; D130058I17Rik; GAB2; KIAA0571; p97
UniProt ID: (Human) Q9UQC2
Entrez Gene ID: (Human) 9846, (Mouse) 14389